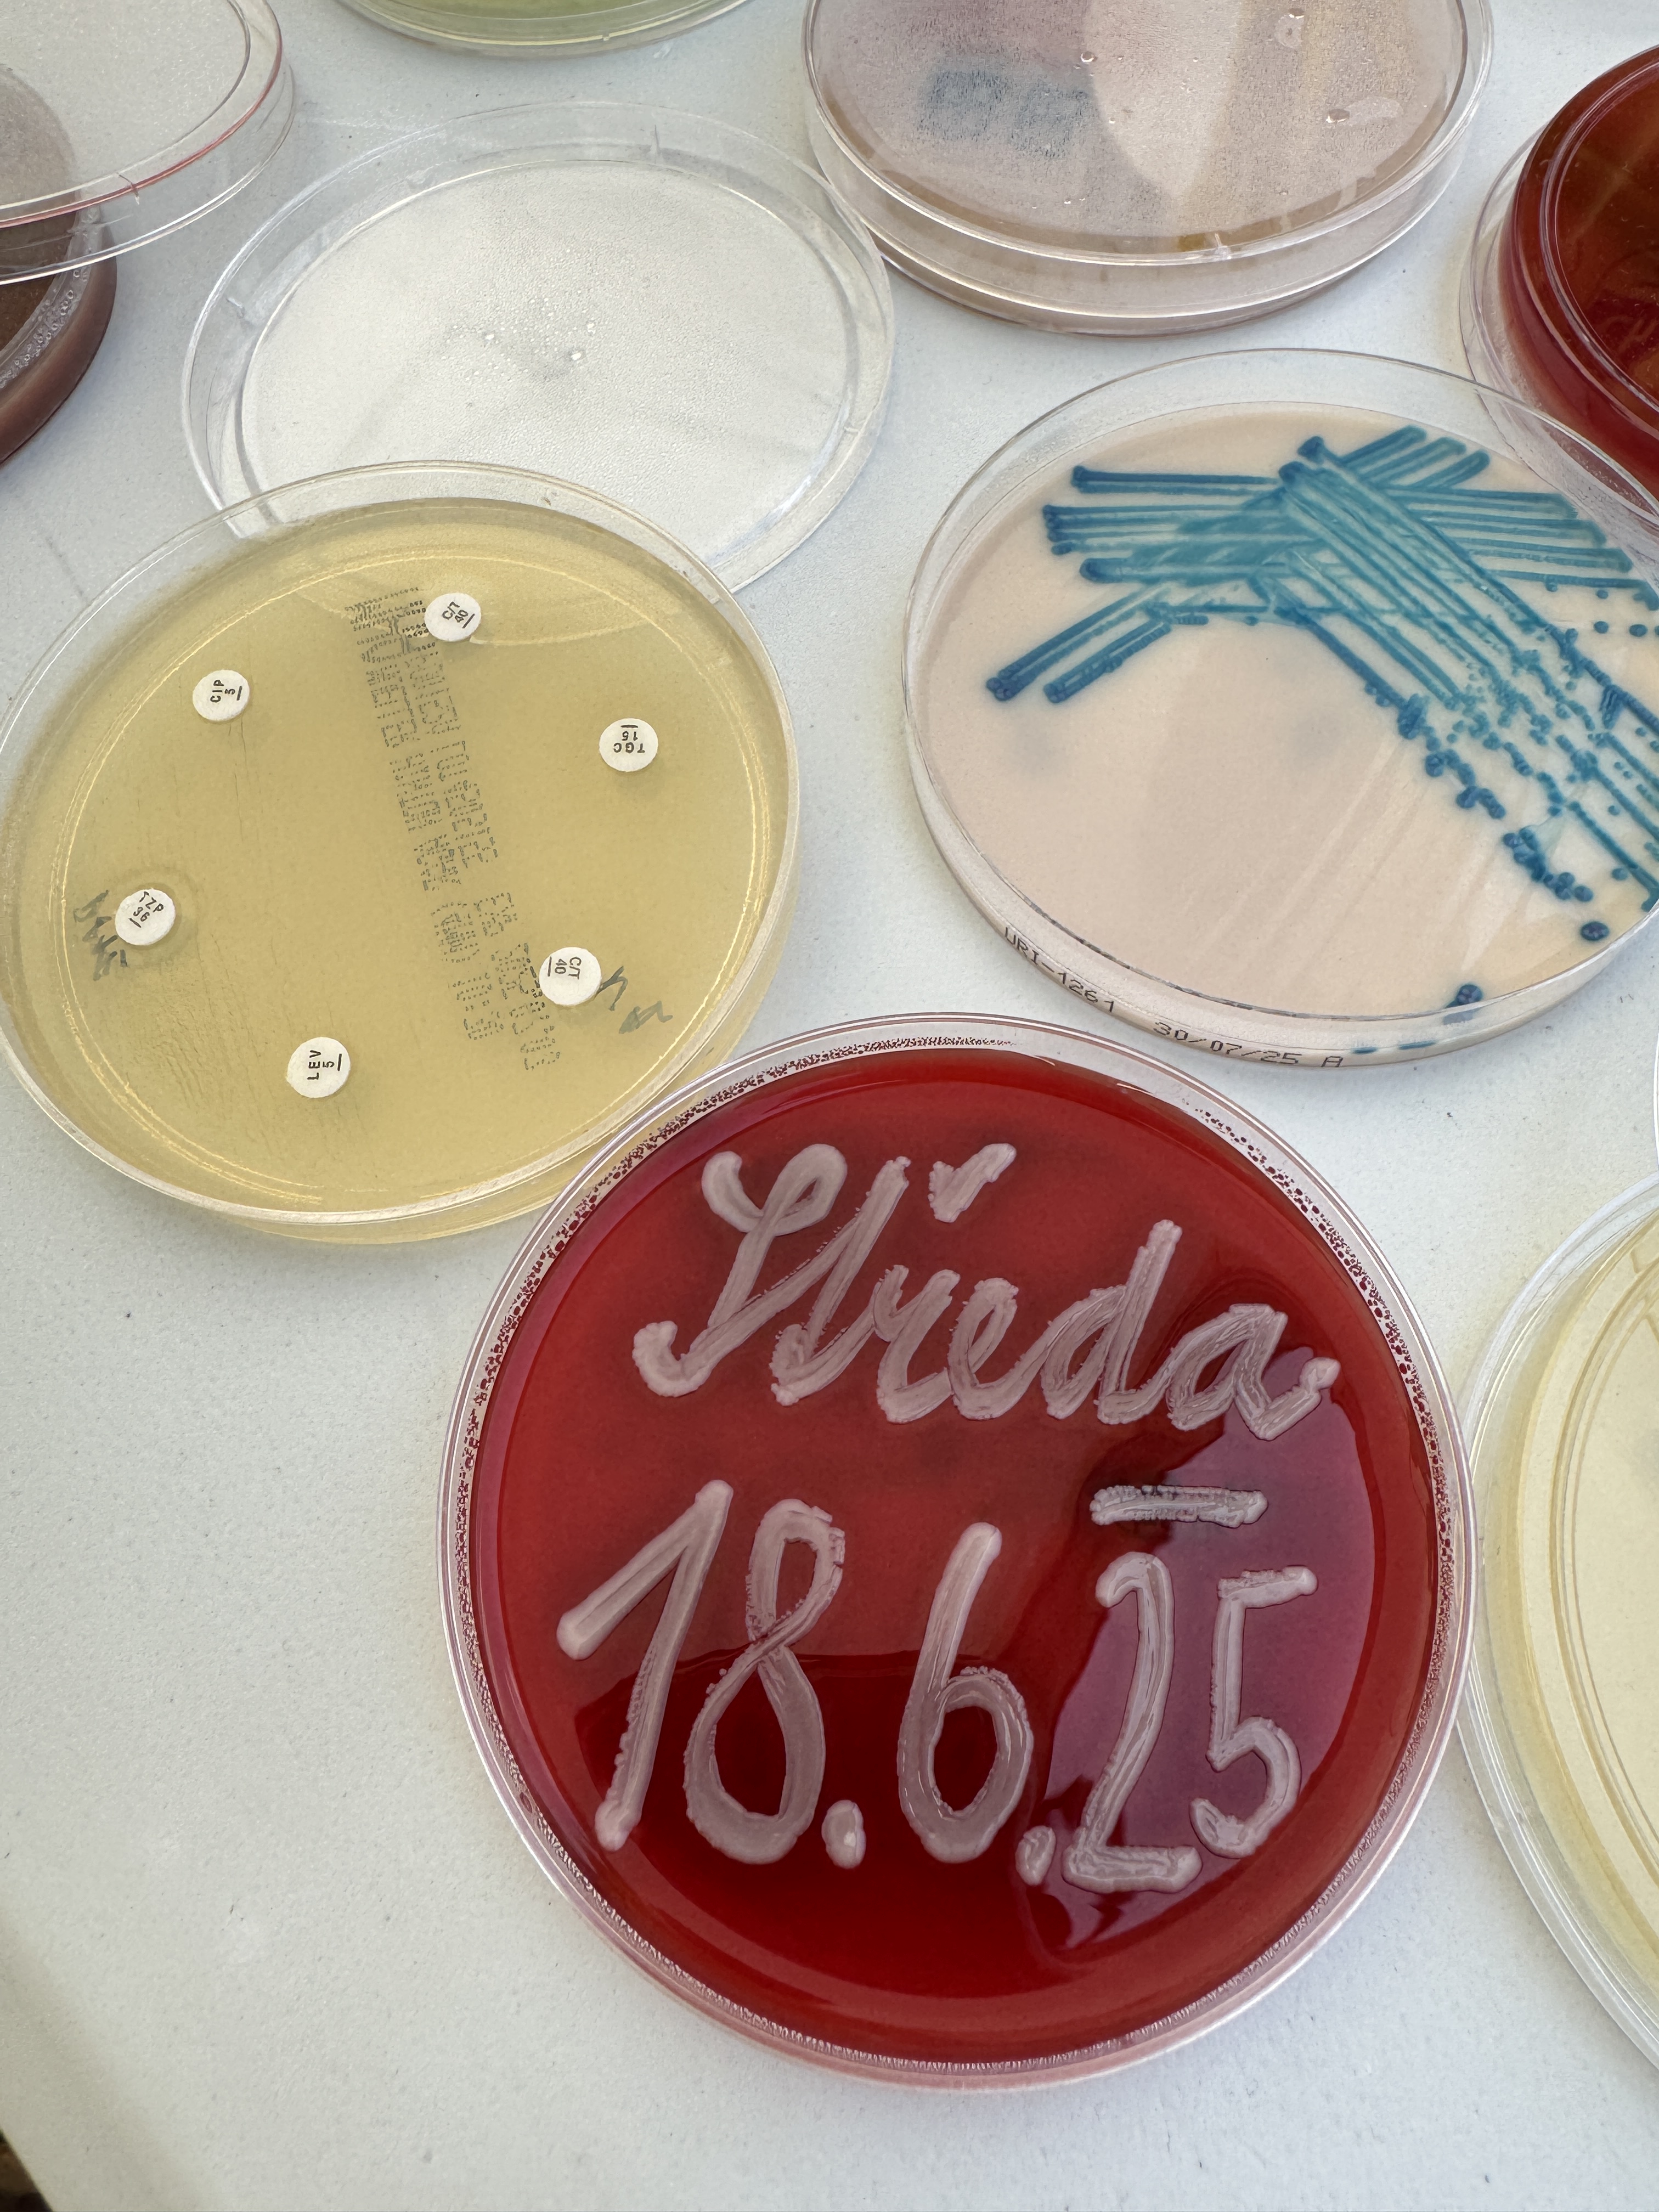

VĚDAFEST 2025
Letošní VědaFest se opět proměnil v živou laboratoř pod širým nebem a náš tým z CZEPAR byl u toho. V rámci našeho stánku jsme návštěvníkům nabídli možnost nejen vidět, ale i sami vyzkoušet postupy, se kterými se běžně setkávají vědci v laboratořích.
Velký zájem budilo také stanoviště věnované moderním metodám molekulární biologie. Díky Janě Wiedermannové a Veronice Kočárkové z Mikrobiologického ústavu Akademie věd se zde mohli účastníci seznámit s principem PCR (polymerázové řetězové reakce) a gelové elektroforézy, technik, které patří k základnímu vybavení každé laboratoře zabývající se DNA. Nechyběla ani možnost vlastní zkušenosti – pipetování si vyzkoušeli jak středoškoláci, tak i ti nejmenší, kteří poprvé drželi laboratorní pomůcku v ruce.
Neméně oblíbený byl korálkový model DNA, který připravila Jana Bartáčková z Ústavu technologie vody a prostředí Vysoké školy chemicko-technologické. Na tomto modelu si zejména děti mohly hravou formou osvojit princip komplementarity nukleotidů. Spojování barevných korálků podle pravidel genetického „kódu“ umožnilo pochopit, jak DNA ukládá informace, a zároveň poskytlo možnost zakódovat krátkou zprávu. Tento model tak ukázal, že složité biologické principy lze přiblížit jednoduchými pomůckami.
Zcela praktický rozměr měl další experiment Jany Bartáčkové, tentokrát s UV lampou, při němž si každý mohl ověřit, zda správně zvládá techniku mytí a dezinfekce rukou. Pod ultrafialovým světlem se snadno odhalilo, která místa byla vynechána – a ukázalo se, že i ti nejpečlivější někdy zapomenou na detaily, například na hřbety rukou či na prostor mezi prsty.
Další možností seznámení s mikrobiologií byly Petriho misky s různými druhy živných agarů, na nichž byly narostlé kolonie bakterií. Gabriela Kroneislová a Jan Závora z Všeobecné fakultní nemocnice návštěvníkům ukázali, jak rozdílně mohou mikroorganismy růst a vypadat v závislosti na prostředí, které jim poskytneme. Tento vizuálně atraktivní prvek pomohl vysvětlit, proč je kultivace mikrobů stále důležitou součástí výzkumu i diagnostiky.
Pro nejmenší zde byly připraveny aktivity, které pomohly seznámit s laboratorními pomůckami, např. rukavicemi. Tyto aktivity zajistila Marta Kořínková ze Státního zdravotního ústavu v Praze.
Celý program doplňovala animovaná pohádka o antimikrobiální rezistenci, kterou připravili Jan Kubele z Nemocnice Na Homolce a Andrea Vávrová z Technické Univerzity v Liberci.
Děkujeme všem, kteří se u našeho stánku zastavili – ať už na chvíli, nebo na delší diskusi. Vaše zvědavost, otázky a nadšení pro vědu nám ukazují, že popularizace výzkumu má smysl. Těšíme se na setkání na dalších akcích, kde vám opět přiblížíme vědu zblízka.